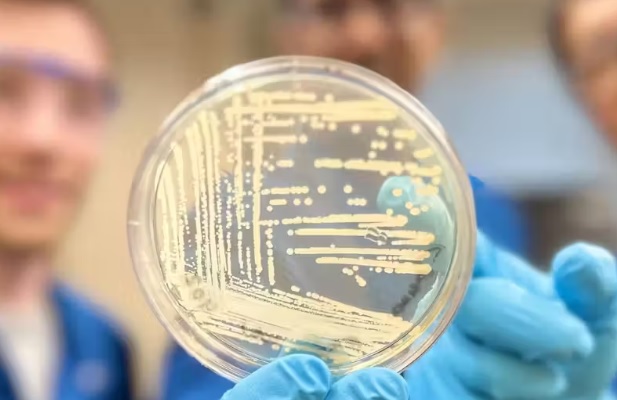
ciencia câncer

Um novo composto, que pode matar superbactérias resistentes a medicamentos, foi desenvolvido por pesquisadores de Harvard. Agora, o futuro de cirurgias, transplantes e até mesmo o tratamento contra o câncer ganham mais um reforço!
O composto sintético foi eficiente contra uma longa lista de cepas como Staphylococcus aureus e Pseudomonas aeruginosa. A molécula tem uma grande eficiência ao se ligar aos ribossomos bacterianos, que controlam a síntese de proteínas da bactéria, dizem os cientistas.
Com a interrupção da função ribossômica mais poderosa, foi possível impedir a resistência das superbactérias a alguns antibióticos. “… nossos resultados mostram uma atividade inibitória significativamente melhorada contra uma longa lista de cepas bacterianas patogênicas que matam mais de um milhão de pessoas todos os anos”, disse Andrew Myers, professor de Química e Biologia Química de Harvard.
Efetivo contra bactérias
Ao longo dos anos, as bactérias foram ficando resistentes a alguns antibióticos.
Foi para combater esse problema que a equipe liderada por Andrew Myers, desenvolveu o composto sintético chamado cresomicina.
“Embora ainda não saibamos se a cresomicina e medicamentos semelhantes são seguros e eficazes em humanos, os nossos resultados mostram uma atividade inibitória significativamente melhorada contra uma longa lista de estirpes bacterianas patogénicas”, explicou.
Guerra contra superbactérias
Para vencer a guerra contra as superbactérias, a equipe de Andrew se baseou nas estruturas químicas das lincosamidas, uma classe de antibióticos comumente prescrita.
Segundo Ben Tresco, aluno da Escola de Pós-Graduação em Artes e Ciência Kenneth C.Griffin, “o ribossomo bacteriano é o alvo preferido da natureza para agentes antibacterianos, esses agentes são a fonte de inspiração para nosso programa”, explicou.
As bactérias desenvolvem resistência a antibióticos direcionados aos ribossomos, expressando genes a produzirem enzimas chamadas RNA metiltransferases ribossômicas.
São essas enzimas que isolam os componentes do medicamento, comumente projetados para perturbar o ribossomo.
Contornando o problema
Para combater o problema, Andrew projetou um composto mais rígido, conferindo uma maior aderência ao ribossomo.
Agora, a ligação ribossómica não necessita gastar tanta energia para se adaptar ao seu alvo, diferente de como os medicamentos existentes já fazem.
Assim, o antibiótico sintético interage diretamente com os pontos fracos das bactérias, conseguindo eliminar os seres microscópicos.
Futuro promissor
O futuro é muito promissor para a cresomicina.
Isso porque a produção da droga envolve um método de construção de grandes componentes moleculares.
Esse tipo de sistema, como a pré-construção de seções de um conjunto de Lego, permite aos pesquisadores produzir e testar não apenas em uma, mas em centenas de moléculas-alvo de uma vez só.
Assim, o processo de descoberta de novos medicamentos é muito acelerado.
“Os antibióticos constituem a base sobre a qual a medicina moderna é construída”, afirmou Kelvin Wu, coautor do estudo e estudante de pós-graduação.
“Sem antibióticos, muitos procedimentos médicos de ponta, como cirurgias, tratamentos de câncer e transplantes de órgãos, não poderiam ser realizados”, lembrou.

Andrew Myers foi o pesquisador responsável por liderar a equipe que desenvolveu o medicamento. Foto: Stephanie Mitchell.
Espalhe Notícia boa!